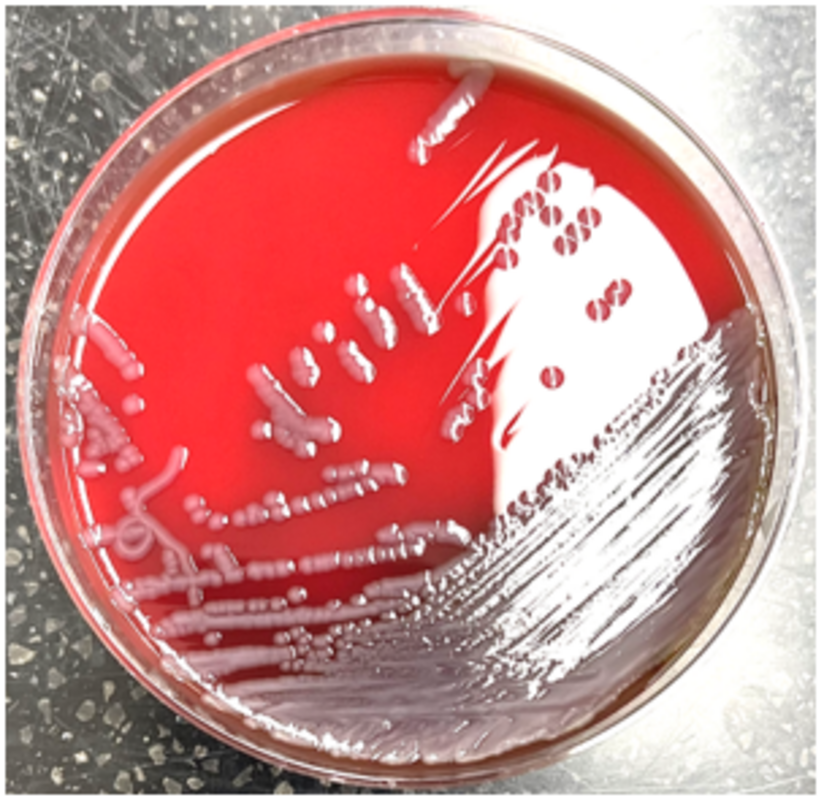
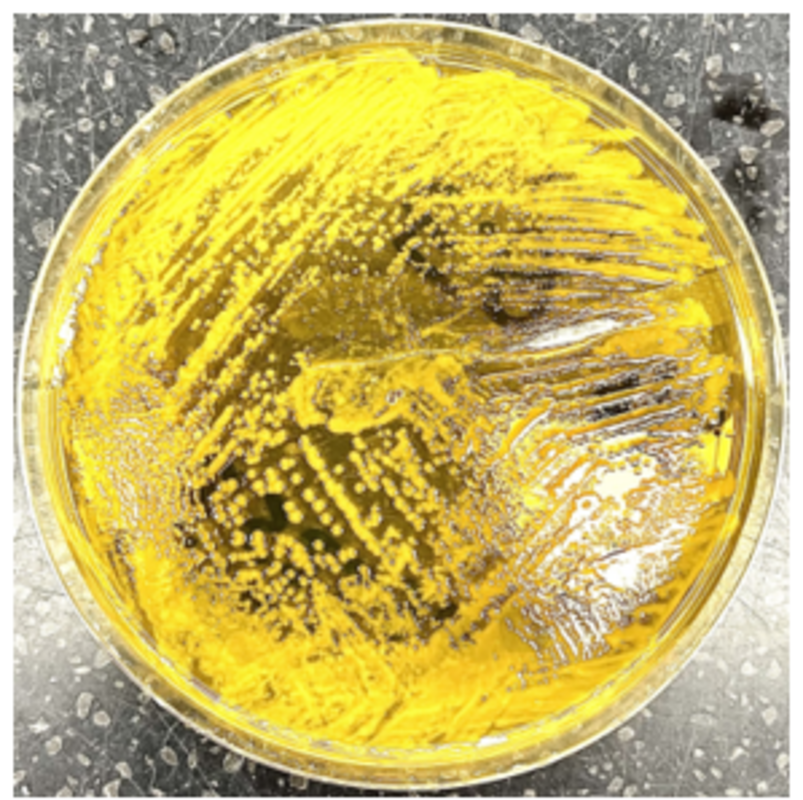

59-летний мужчина поступил в отделение неотложной помощи с кровотечением из прямой кишки, сопровождавшимся тошнотой, рвотой, спазмами в животе и непрекращающейся водянистой диареей.
Несколькими днями ранее он вернулся из трехнедельной поездки в Доминиканскую Республику. При физикальном осмотре он был афебрилен. Живот был мягким, не напряженным и не вздутым.
Образец кала был отправлен в микробиологическую лабораторию для проведения ПЦР-теста, в результате которого была обнаружена Vibrio cholera. Затем кал был посеян на питательные среды. На чашке кровяного агара выросли гемолитические колонии (иллюстрация 1), а на тиосульфатно-цитратно-желчном сахарозном селективном агаре выросли желтые (цвет исходной среды зеленый) колонии из-за ферментации сахарозы (иллюстрация 2). При окраске по Граму этих колоний были обнаружены грамотрицательные, изогнутые, в форме запятой палочки (иллюстрация 3), а идентификация методом MALDI-ToF выявила Vibrio albensis. Образец был отправлен в централизованную лабораторию для подтверждения, которая сообщила об идентификации Vibrio cholerae O1 серовара Ogawa с O1 антигеном.
Иллюстрация 1. Рост на кровяном агаре
Иллюстрация 2. Ферментация TCBS агаре с сахарозой

Иллюстрация 3. Грамотрицательные, изогнутые, запятообразные палочки
Обсуждение
Vibrio albensis - граммотрицательная галофильная бактерия, принадлежащая к семейству Vibrionaceae. V. albensis - недавно обнаруженный вид рода Vibrio, который, как полагают, является членом комплекса Vibrio cholera. Хотя в основном вид V. albensis считается непатогенным, с ним связаны редкие случаи инфицирования людей, особенно лиц с ослабленной иммунной системой.
Хотя результаты ранее проведенных исследований данного пациента указывали на то, что V. albensis относится к серогруппе V. cholerae не O1 и не O130, централизованная лаборатория подтвердила принадлежность изолята к O1 серовару Ogawa путем типирования антигена O1. V. albensis является новым патогеном с ограниченной информацией о его клиническом значении и оптимальном лечении. Инфекции преимущественно связаны с загрязненной морской водой или морепродуктами. Основной путь передачи - через открытые раны или при употреблении сырых или недостаточно обработанных морепродуктов.
Клинические проявления этого микроорганизма могут быть похожи на V. cholerae, например, диффузная водянистая диарея, отличительный признак холеры, или бессимптомными. В других случаях сообщалось о бактериемии, септицемии и инфекциях мочевыводящих путей.
Лабораторная диагностика инфекции Vibrio cholerae albensis заключается в выделении и идентификации бактерии из образцов кала. Этого можно достичь с помощью селективных культуральных сред, таких как TCBS агар, который позволяет культивировать V. cholerae и ее разновидности.
Антимикробная резистентность вызывает растущую озабоченность при лечении холеры. В исследованиях сообщалось о различных уровнях резистентности к широко используемым антибиотикам у V. cholerae, включая V. cholerae albensis. Очень важно отслеживать структуру чувствительности к антимикробным препаратам, чтобы определить соответствующие стратегии лечения. Необходимы дальнейшие исследования, чтобы лучше понять эпидемиологию, клинические проявления и оптимальные стратегии лечения инфекций, вызванных V. albensis, поскольку члены комплекса V. cholerae выявляются/распознаются с помощью более совершенных диагностических инструментов.
